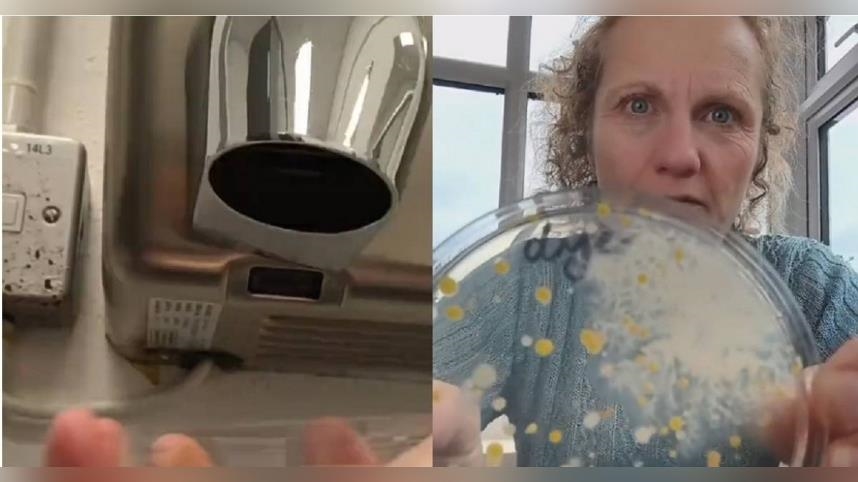
洗手後愛用烘手機？專家實驗見爆量細菌　眾人嚇壞：不敢用了

洗手後愛用烘手機?專家實驗見爆量細菌 眾人嚇壞:不敢用了
 2025-11-07 17:31
2025-11-07 17:31
- 小
- 中
- 大
圖、文/CTWANT捷運、賣場或百貨公司的公廁大多附設有烘手機,提供民眾洗手後可以把手烘乾。近期英國一名專家特地到公廁實驗,意外發現烘手機吹出的細菌數量比廁所空間還多,如果民眾用烘手機烘乾手等於手也白洗了。影片曝光後,一眾網友看完直呼,「以後不敢再用了」。
圖、文/CTWANT
捷運、賣場或百貨公司的公廁大多附設有烘手機,提供民眾洗手後可以把手烘乾。近期英國一名專家特地到公廁實驗,意外發現烘手機吹出的細菌數量比廁所空間還多,如果民眾用烘手機烘乾手等於手也白洗了。影片曝光後,一眾網友看完直呼,「以後不敢再用了」。
英國一家教育機構「Devon Science」曾在影音平台分享發現廁所烘手機上,附著爆量細菌的影片,一度引發熱烈討論。近日先前做實驗的女老師Ruth MacLaren再次進行實驗,用4個培養皿,分別採集烘手機出風口、廁所空間、洗手前、洗手後用烘手機的細菌進行對照。最終發現烘手機出風口的培養皿布滿細菌,比廁所環境還多。
實驗結果可見洗手前的培養皿細菌,和洗完手後用烘手機的細菌量差不多,換句話說,洗手後用烘手機烘乾,等於沒有洗手。影片目前已超過1400萬人次觀看,底下更有上萬則留言討論,網友們紛紛驚呼,「以後不敢用烘手機,乖乖用擦手紙」、「天啊!超喜歡用烘手機,發瘋」;有人則表示,「好險我本來就不愛用」、「絕對不會用這種機器」。
有台灣網友將影片分享到社群平台Threads,引發熱烈討論,「以前就聽過烘手機不乾淨,所以我洗手都不用烘手機」、「哇好險我都用衣服或褲子擦乾」、「謝謝,以後不烘手了」;但有網友不以為意,「正常人的手不是培養皿,放好幾天長出黴菌,只是實驗罷了,想用就用,不想用就不要用」。
延伸閱讀
免責聲明:本文為合作外稿授權《民視新聞網》原文轉載,如對內文有任何疑問請逕與原作單位確認。
【原文出處】:洗手後愛用烘手機?專家實驗見爆量細菌 眾人嚇壞:不敢用了
延伸閱讀

男釣魚誤碰高壓電身亡 供電公司被判賠百萬:電線高度不符規範
2025-11-07 17:24
 {PLAYICON}
{PLAYICON}童言哭喊「老師不要Finger inside!」 虐童153次幼師求復職 法院判決出爐
2025/11/07 17:27:07

屏東特斯拉高速撞水泥車「噴飛」再撞4貼機車 釀1死7傷、兩家庭破碎
2025-11-07 17:24
 {PLAYICON}
{PLAYICON}懷孕20週驚見卵巢癌!跨科團隊保留子宮保胎至足月
2025/11/07 17:27:14

用這款鼻通恐傷身?馬來西亞全面禁售「Hong Thai鼻通2」 違法販售恐判3年罰新台幣35萬
2025-11-07 17:31
 {PLAYICON}
{PLAYICON}藍營又造謠?張麗善喊「湖山水庫別設光電」 經濟部打臉:未發函
2025/11/07 17:24:39

